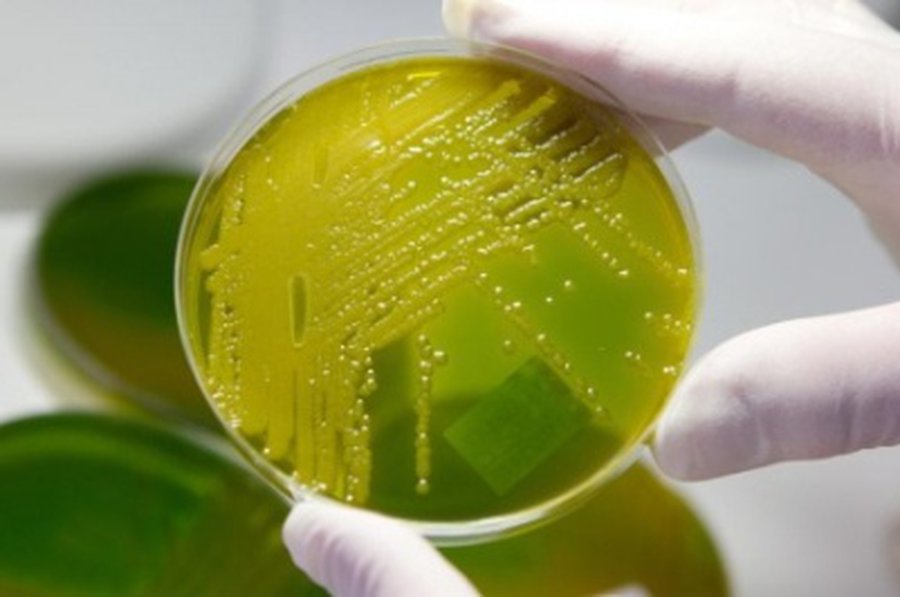
Mirtinas E. coli protrūkis Vokietijoje baigėsi - Pasaulyje

Vokietijoje kilęs mirtinas E. coli protrūkis, pražudęs daugiau kaip 50 žmonių, baigėsi, antradienį pareiškė šalies sveikatos apsaugos tarnybos.:::Roberto Kocho institutas, Vokietijos nacionalinis lygų kontrolės centras, pranešė, kad paskutinis naujas enterohemoraginės E. coli atvejis užfiksuotas prieš tris savaites, o tiek trunka ligos inkubacinis laikotarpis, informuoja naujienų agentūra AFP. „Kadangi institutas nuo to laiko negavo pranešimu apie jokias naujas infekcijas, susijusias su šiuo protrūkiu, institutas laikosi nuomonės, kad protrūkis baigėsi“, – teigiama pranešime.
Teigiama, kad ypač pavojingos bakterijos atmainos, pareikalavusios 50 žmonių gyvybių ir susargdinusios dar daugiau kaip 4 tūkst., stebėsena bus tęsiama.
Protrūkis didžiausią mastą pasiekė gegužės pabaigoje. Europos maisto saugumo agentūra šį mėnesį paskubomis uždraudė platinti egiptietiškas sėklas ir pupeles, kai dėl infekcijos protrūkio apkaltintos užkrėstos į Vokietiją importuotos ir tuomet kitus išplatintos vaistinės ožragės sėklos.
Vėliau šios sėklos naudotos salotų daigams auginti, kurių prieš susirgdamos ir valgė dauguma aukų. Vokietijos pareigūnai iš pradžių dėl infekcijos protrūkio klaidingai apkaltino ispaniškus agurkus. Tai pačiame šviežių daržovių sezono įkarštyje padarė daug nuostolių šalies žemės ūkiui ir sukėlė įtampa abiejų šalių santykiuose.
lrt.lt
Mirtinas E. coli protrūkis Vokietijoje baigėsi
Komentarai
Norint komentuoti, reikia prisijungti prie Facebook (Meta) paskyros
Pasaulyje
kitos naujienos šiame skyriuje →
„Amazon“ koreguoja planus ir skelbia iš viso atleisianti per 18 tūkst. darbuotojų

Per žemės drebėjimą Filipinuose žuvo mažiausiai 4 žmonės, 60 sužeista

„Lietuvos geležinkeliai“: pirmadienį buvo priimtas pirmasis traukinys vežimui per Lietuvos teritoriją į Kaliningradą

Sveikatos apsaugos ministras su oficialiu darbo vizitu lankosi Kipre

ES patvirtino dar 500 mln. eurų karinę paramą Ukrainai

Ukraina ir Rusija pasirašė susitarimą dėl grūdų eksporto

Miškų gaisrai iš Italijos persimetė į Slovėniją, evakuoti keturi kaimai
